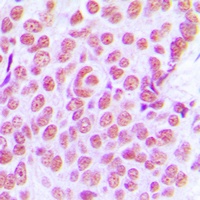
c-Jun Antibody抗体，orb214140，bio

相关产品推荐更多 >
万千商家帮你免费找货
0 人在求购买到急需产品
- 详细信息
- 技术资料
- 抗体名:
c-Jun Antibody抗体
- 抗体英文名:
c-Jun Antibody
- 应用范围:
EMSA, IHC, IP, WB
- 宿主:
Rabbit
- 适应物种:
Bovine, Gallus, Human, Mouse, Porcine, Rat
- 保质期:
6-12个月
- 抗原来源:
详询
- 目录编号:
orb214140
- 级别:
科研级
- 库存:
88
- 供应商:
biorbyt
- 标记物:
Unconjugated
- 克隆性:
Polyclonal
- 形态:
Liquid in 0.42% Potassium phosphate, 0.87% Sodium chloride, pH 7.3, 30% glycerol, and 0.01% sodium azide.
- 免疫原:
KLH-conjugated synthetic peptide encompassing a sequence within the center region of human c-Jun. The exact sequence is proprietary.
- 规格:
30 ul
产品描述:The c-Jun Antibody is suitable for EMSA, IHC, IP, WB. It is a Polyclonal, Unconjugated antibody which raised against KLH-conjugated synthetic peptide encompassing a sequence within the center region of human c-Jun. The exact sequence is proprietary. Purification: The antibody was purified by immunogen affinity chromatography.
别名:Transcription factor AP-1; Activator protein 1; AP1; Proto-oncogene c-Jun; V-jun avian sarcoma virus 17 oncogene homolog; p39
免疫原:KLH-conjugated synthetic peptide encompassing a sequence within the center region of human c-Jun. The exact sequence is proprietary.
应用稀释比例:WB: 1-500-1-1000, IHC-P: 1-100-1-200, IP: 1-10-1-100
纯化:The antibody was purified by immunogen affinity chromatography.
保存说明:Maintain refrigerated at 2-8°C for up to 2 weeks. For long term storage store at -20°C in small aliquots to prevent freeze-thaw cycles.
Entrez:16476, 3725, 24516
UniProt ID:P17325, P05627, P05412
Note:For research use only.


别名:Transcription factor AP-1; Activator protein 1; AP1; Proto-oncogene c-Jun; V-jun avian sarcoma virus 17 oncogene homolog; p39
免疫原:KLH-conjugated synthetic peptide encompassing a sequence within the center region of human c-Jun. The exact sequence is proprietary.
应用稀释比例:WB: 1-500-1-1000, IHC-P: 1-100-1-200, IP: 1-10-1-100
纯化:The antibody was purified by immunogen affinity chromatography.
保存说明:Maintain refrigerated at 2-8°C for up to 2 weeks. For long term storage store at -20°C in small aliquots to prevent freeze-thaw cycles.
Entrez:16476, 3725, 24516
UniProt ID:P17325, P05627, P05412
Note:For research use only.

Western blot analysis of c-Jun expression in HeLa (A), mouse kidney (B), PC12 (C) whole cell lysates. (Predicted band size: 35 kD; Observed band size: 43 kD)
Immunohistochemical analysis of c-Jun staining in human breast cancer formalin fixed paraffin embedded tissue section. The section was pre-treated using heat mediated antigen retrieval with sodium citrate buffer (pH 6.0). The section was then incubated with the antibody at room temperature and detected using an HRP conjugated compact polymer system. DAB was used as the chromogen. The section was then counterstained with haematoxylin and mounted with DPX.
风险提示:丁香通仅作为第三方平台,为商家信息发布提供平台空间。用户咨询产品时请注意保护个人信息及财产安全,合理判断,谨慎选购商品,商家和用户对交易行为负责。对于医疗器械类产品,请先查证核实企业经营资质和医疗器械产品注册证情况。
技术资料暂无技术资料 索取技术资料
c-Jun Antibody抗体,orb214140,biorbyt
¥1560










